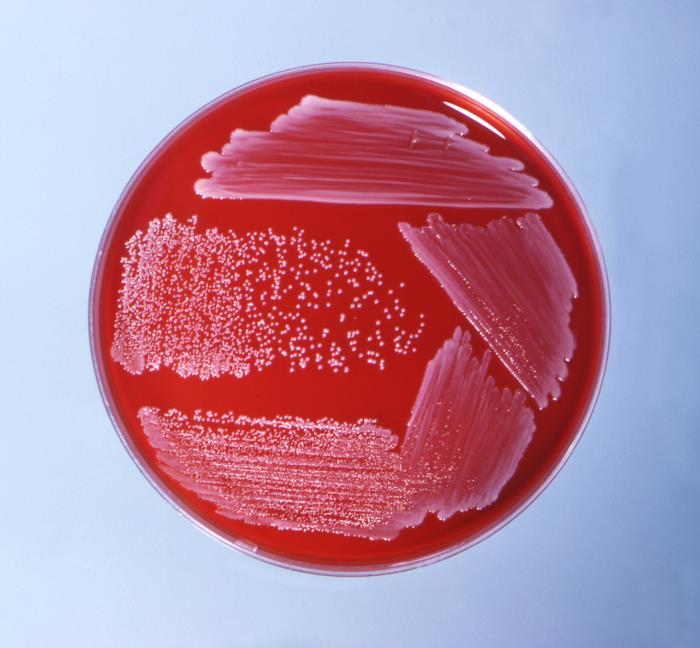
Colonias de C. ulcerans. CDC Public Health Image Library (PHIL).
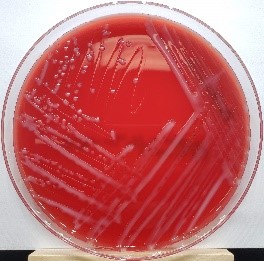
Pasteurella multocida

Bacterias
El RD 664/1997, de 12 de mayo, sobre la protección de los trabajadores contra los riesgos relacionados con la exposición a agentes biológicos durante el trabajo; expone en su artículo 2 que se entenderán por agentes biológicos los microorganismos, con inclusión de los genéticamente modificados, cultivos celulares y endoparásitos humanos, susceptibles de originar cualquier tipo de infección, alergia o toxicidad.
Las bacterias son microorganismos procariotas, es decir, organismos unicelulares de pocos micrómetros de tamaño. Poseen una membrana plasmática, compuesta de lípidos y proteínas, que encierra y protege la célula y una pared celular, que constituye la barrera física y mecánica que da forma a la bacteria.
Según su forma se pueden distinguir diferentes tipos de bacterias (cocos, bacilos, vibrios o vibriones, espirilos y espiroquetas). En función de la tinción de Gram podemos clasificarlas en bacterias Gram positivo y Gram negativo. Las bacterias Gram negativo presentan en su pared celular endotoxinas, las cuales pueden tener efectos tóxicos en el organismo. Por otro lado, las bacterias, en su mayoría las Gram positivo, producen y liberan exotoxinas que están asociadas a enfermedades infecciosas, por ejemplo, la toxina botulínica y la tetanospasmina.
Solo una pequeña parte de las bacterias son patógenas para los seres humanos, sin embargo, son una de las principales causas de enfermedades, causando infecciones como el carbunco, brucelosis, salmonelosis, listeriosis, tos ferina, enfermedad de Lyme, tuberculosis y tétanos.
Entre las actividades profesionales más expuestas encontramos aquellas relacionadas con la producción de alimentos, por ejemplo la fabricación de productos lácteos o el procesado y conservación de carne y elaboración de productos cárnicos; el sector agrícola; las actividades en las que existe contacto con animales o productos de origen animal, como la pesca y acuicultura, los veterinarios o la producción de pieles y lana; los trabajos de asistencia sanitaria; las actividades en unidades de eliminación de residuos; y los trabajos en instalaciones depuradoras de aguas residuales.